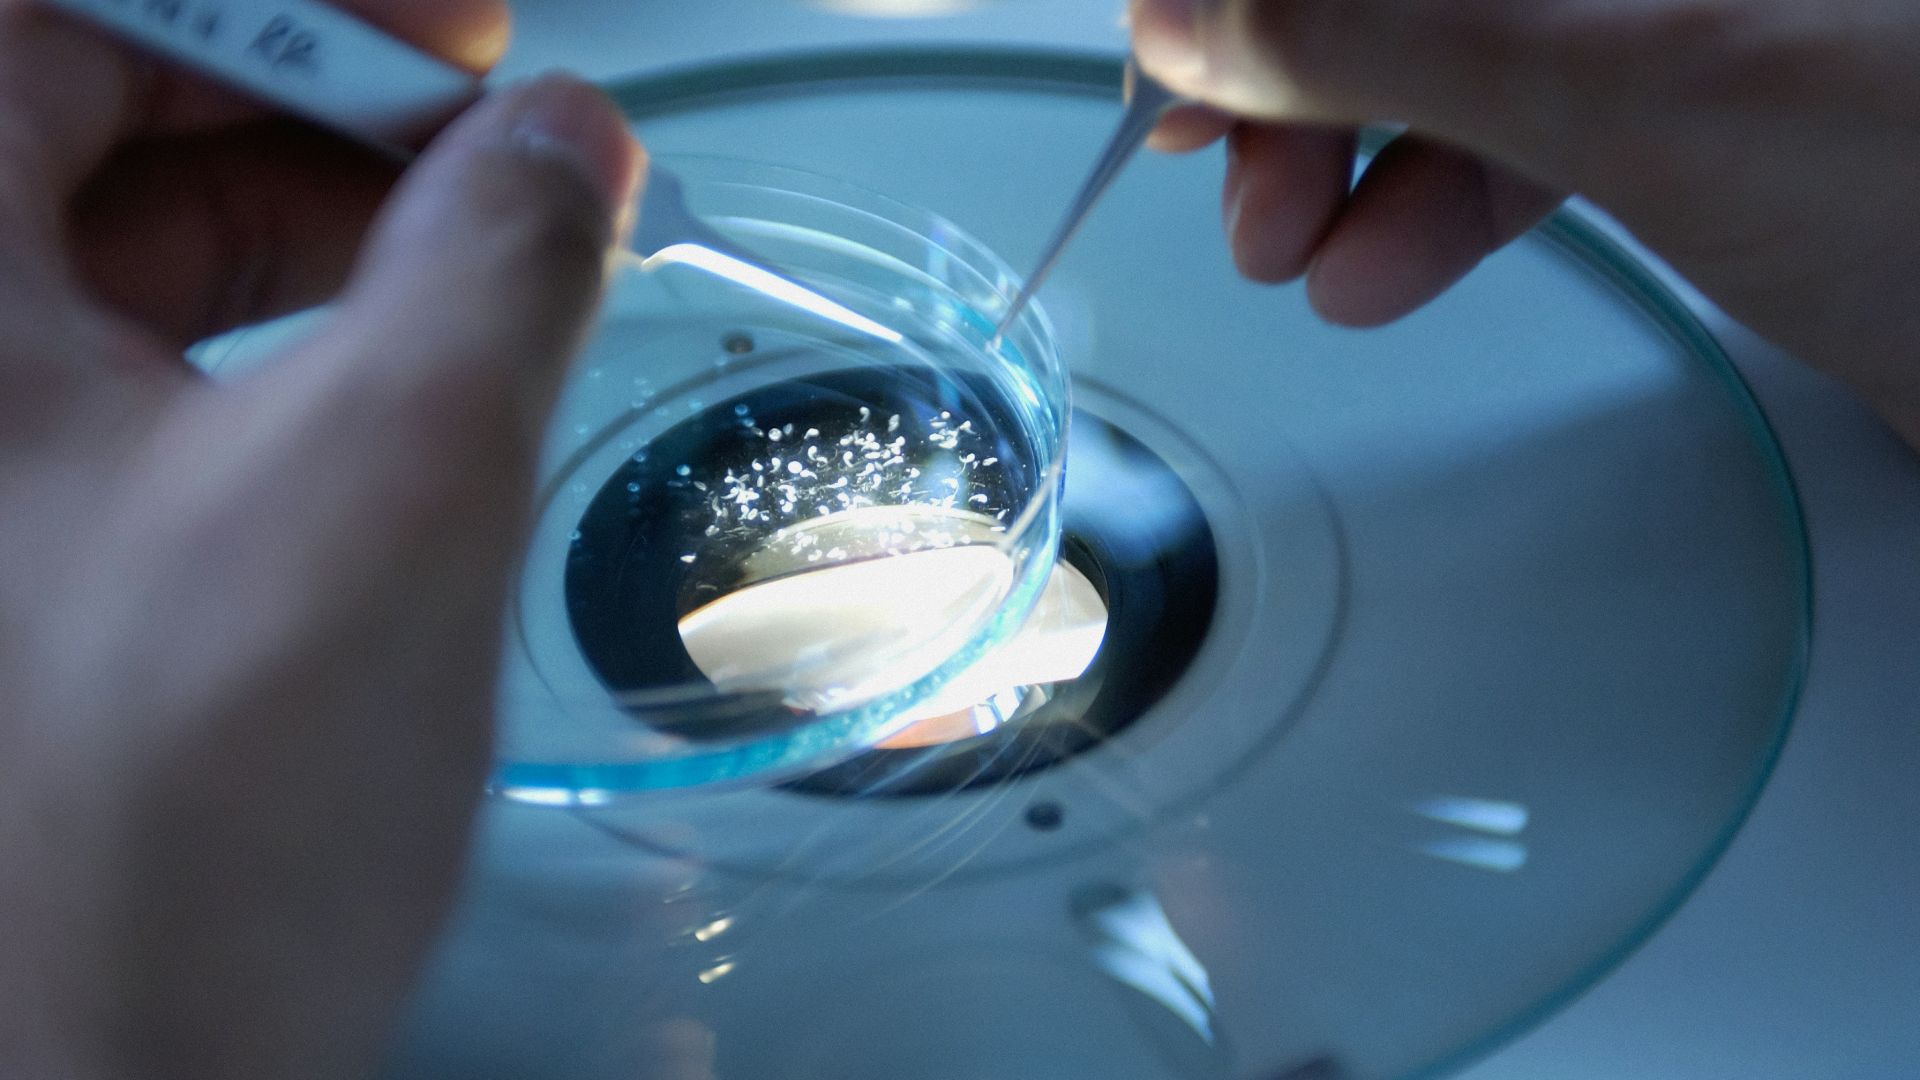
a close up of a person holding a toothbrush

A Mystery as Old as Humanity
For centuries, we’ve asked the same impossible question: What is life—and what gives it meaning? Now, scientists think they’re closer than ever to answering it. But their explanation isn’t philosophical or spiritual—it’s something far more concrete, hidden deep within the structure of matter itself.
The Question That Never Went Away
Every civilization has wrestled with the question of life’s meaning. Religions, poets, and philosophers have all taken their turn. But scientists have long struggled with a simpler version of that question—what exactly makes something alive in the first place?
The Scientific Dilemma
Defining life has never been simple. Is it reproduction? Growth? Metabolism? Even NASA’s official definition—“a self-sustaining chemical system capable of Darwinian evolution”—leaves holes. Some viruses don’t qualify. Some computer models nearly do. Clearly, something fundamental was missing.
A New Clue from Chemistry
A growing number of scientists began asking: what if life isn’t about what it does—but how it’s built? Maybe the secret to life lies in the steps it takes to construct itself, not the ingredients it uses.
The Start of a Radical Idea
That question led Dr. Sara Imari Walker of Arizona State University and Prof. Lee Cronin of the University of Glasgow to develop a bold new framework. They called it Assembly Theory—and it just might rewrite how we define life.
 Alien Debate: Sara Walker and Lee Cronin | Lex Fridman Podcast #279, Lex Fridman
Alien Debate: Sara Walker and Lee Cronin | Lex Fridman Podcast #279, Lex Fridman
A Theory Born from Curiosity
Walker and Cronin weren’t looking for philosophy—they were chasing a pattern. They wanted a quantitative way to distinguish between random molecules and those built through biological processes. The result was a theory that measures life by its construction history.
What Assembly Theory Actually Says
At its core, Assembly Theory looks at how difficult it is to build a molecule from scratch. The more unique steps needed, the higher its “assembly index.” Molecules from living systems usually require far more steps—meaning they carry a kind of chemical memory.
The “Assembly Index” Explained
The Assembly Index counts the minimum number of building steps needed to make a molecule. The higher the number, the less likely it could form randomly. That threshold becomes a measurable signal of life—or something life-like—at work.
Why Complexity Matters
Simple molecules like methane or water form easily through basic chemistry. But something like a protein or DNA strand involves dozens or hundreds of precise steps. That complexity, according to Assembly Theory, is where life’s fingerprint hides.
Measuring Life by Its History
Instead of focusing on DNA or cells, Assembly Theory tracks how much “history” a molecule carries. It’s not just what a molecule is—it’s how much effort the universe had to invest to make it.
A Universal Signature of Life
Because it’s based on construction complexity, Assembly Theory doesn’t rely on Earth-specific chemistry. Any system—on any planet—that produces molecules with high assembly indices could be considered alive. It’s a universal measure of life’s process.
 National Institute of Allergy and Infectious Diseases, Unsplash
National Institute of Allergy and Infectious Diseases, Unsplash
Detecting Life Without Seeing It
For astrobiology, this changes everything. You see, now Instead of searching for water or oxygen, scientists could analyze molecular fingerprints to detect life. A single high-complexity molecule could possibly even reveal what no telescope could ever show.
From the Lab to the Stars
In lab experiments, researchers compared organic and inorganic samples. Only biological materials consistently produced high assembly indices. And that difference held even when the samples were reduced to tiny fragments—proof that the signal of life is measurable and robust.
National Cancer Institute, Unsplash
National Cancer Institute, Unsplash
Validated by Experiments
In 2023 and 2024, multiple studies confirmed the pattern. Using mass spectrometry and modeling, scientists found that only systems capable of evolution and memory produce high assembly index molecules. Random chemistry simply can’t reach those levels of complexity.
 IAEA Imagebank, Wikimedia Commons
IAEA Imagebank, Wikimedia Commons
Why Random Chemistry Doesn’t Cut It
Chemistry alone can form simple compounds. But life builds with intentionality—layering steps, storing patterns, and repeating success. Assembly Theory turns that process into a measurable signature that separates biology from pure chance.
Complexity Becomes Meaning
Under this view, meaning isn’t mystical—it’s measurable. Life is what happens when matter begins to record its own construction through increasing complexity. Meaning is literally embedded in the way life builds itself.
From Philosophy to Physics
Philosophers see meaning as purpose. Assembly Theory reframes it as process. Meaning comes from how information accumulates—how systems remember what they’ve made and evolve on top of it.
A Bridge Between Life and Matter
Assembly Theory blurs the line between physics and biology. Life isn’t a special exception—it’s what happens when matter crosses a threshold of complexity and starts building on its own history.
 NASA, ESA, J. Hester and A. Loll (Arizona State University), Wikimedia Commons
NASA, ESA, J. Hester and A. Loll (Arizona State University), Wikimedia Commons
The Search for Alien Life Changes
NASA and other agencies are already exploring ways to use Assembly Theory. Future missions might carry sensors that scan for molecular assembly signatures—a potential way to detect life without ever seeing it.
 NASA Glenn Research Center / NASA/Sara Lowthian-Hanna, Wikimedia Commons
NASA Glenn Research Center / NASA/Sara Lowthian-Hanna, Wikimedia Commons
Beyond Space: Earthly Applications
The same logic could apply here on Earth. Scientists are testing whether Assembly Theory can help identify synthetic life forms, track evolutionary complexity, or even guide artificial intelligence systems that learn in similar self-building ways.
Life as an Inevitable Process
If this theory holds, life might not be rare at all. It could be an inevitable consequence of chemistry reaching a certain threshold. The universe, given enough time, may naturally produce systems that learn, remember, and evolve.
From Molecules to Minds
That logic scales upward. If simple molecules can encode history, then consciousness itself might be the most advanced form of assembly. Life, in this view, is the universe learning to know itself.
Why It’s Called “The Meaning of Life”
When scientists use that phrase, they mean something tangible: life is matter with memory. Each living thing carries a record of the steps that built it—a measurable history that defines its existence.
A New Way to Think About Existence
In this light, life isn’t an accident—it’s a pattern. The “meaning of life” isn’t hidden in philosophy or faith. It’s written in the chemistry of things that learn to build themselves—and keep going.
You Might Also Like:
























